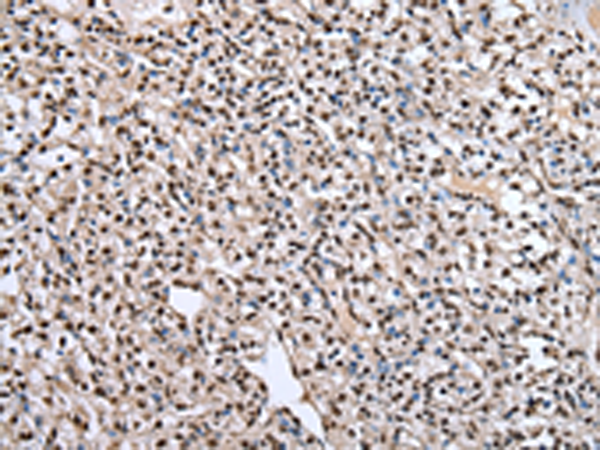
一抗

中文名稱: 兔抗PTBP1多克隆抗體
英文名稱: Anti-PTBP1 rabbit polyclonal antibody
別 名: PTB; PTB2; PTB3; PTB4; pPTB; HNRPI; PTB-1; PTB-T;
相關(guān)類別: 一抗
儲(chǔ) 存: 冷凍(-20℃) 避光
抗 原: PTBP1
宿 主: Rabbit
反應(yīng)種屬: Human, Mouse, Rat
標(biāo) 記 物: Unconjugate
克隆類型: rabbit polyclonal
技術(shù)規(guī)格
|
Background: |
This gene belongs to the subfamily of ubiquitously expressed heterogeneous nuclear ribonucleoproteins (hnRNPs). The hnRNPs are RNA-binding proteins and they complex with heterogeneous nuclear RNA (hnRNA). These proteins are associated with pre-mRNAs in the nucleus and appear to influence pre-mRNA processing and other aspects of mRNA metabolism and transport. While all of the hnRNPs are present in the nucleus, some seem to shuttle between the nucleus and the cytoplasm. |
|
Applications: |
WB, IHC |
|
Name of antibody: |
PTBP1 |
|
Immunogen: |
Fusion protein of human PTBP1 |
|
Full name: |
polypyrimidine tract binding protein 1 |
|
Synonyms: |
PTB; PTB2; PTB3; PTB4; pPTB; HNRPI; PTB-1; PTB-T; HNRNPI; HNRNP-I |
|
SwissProt: |
P26599 |
|
IHC positive control: |
Human prostate cancer and Human liver cancer |
|
IHC Recommend dilution: |
25-100 |
|
WB Predicted band size: |
57 kDa |
|
WB Positive control: |
Hela, hepg2 and HT-29 cell |
|
WB Recommended dilution: |
200-1000 |


 購(gòu)物車
購(gòu)物車 幫助
幫助
 021-54845833/15800441009
021-54845833/15800441009